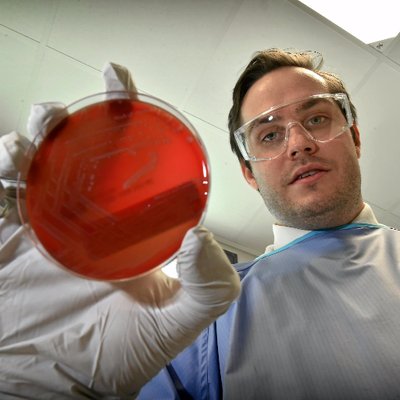

Page Overview:
Search results for Adam Stewart reveal multiple individuals. Social media platforms show 14 Facebook, 21 Instagram, 10 TikTok, 17 Twitter, 10 Quora, 48 Flickr, and 9 MySpace profiles. Public records identify Adam A Stewart, Adam R Stewart, Adam P Stewart, Adam S Stewart, Adam Vincent Stewart, Adam Pommier Stewart, Adam B Stewart, Adam Romney Stewart, Adam C Stewart, Adam Stewart (age 43), Adam Michael Stewart (age 43, Washington (WA)), Adam Stewart (age 44), Adam Lee Stewart (age 46), Adam S Stewart (age 52), Adam A Stewart (age 54), and Adam M Stewart. Addresses are listed for some individuals: Adam A Stewart at ***** 5th Ave, New York, NY; Adam R Stewart at ***** Ga Highway 102, Stapleton, GA; Adam P Stewart at ***** Ga Highway 83 N, Forsyth, GA; and Adam S Stewart at ***** Silent Springs Rd, Candler, NC. Web results mention Adam Stewart as the Executive Chairman of Sandals Resorts International, and detail his role in the company, including alleged delays in payouts and the passing of his wife, Jill Stewart. Other web results highlight his leadership of multiple companies and his family's involvement in the Sandals Resorts business.
Adam T Stewart, age 34, Houston, TX View Details
Cities: Houston TX, Friendswood TX Possible Relatives: Gary Todd Stewart, Kay Lynn Stewart, Tommy Stephen Stewart
Adam M Stewart, age 42, Mckinney, TX View Details
Cities: Mckinney TX, Greendale WI Possible Relatives: Lynnette Marie Brooks, Hannah R Koehn, Jampa Mackenzie Stewart
Adam Stewart, age 27, San Antonio, TX View Details
Cities: San Antonio TX Possible Relatives: Abigail Renee Stewart, Bettie L Stewart, Billie Stewart
Adam Stewart, age 51, Fort Hood, TX View Details
Cities: Fort Hood TX
Adam Andrew Stewart, age 25, Brownsville, TX View Details
Cities: Brownsville TX Possible Relatives: Andrew Arvin Stewart, Arvin A-vlb Stewart, Patricia Lynn Stewart
Adam B Stewart, age 37, Dallas, TX View Details
Cities: Dallas TX Possible Relatives: Betty J Stewart, Jeanann Bryant Stewart, Rebecca L Stewart
Adam C Stewart, age 34, Denton, TX View Details
Cities: Denton TX, Anna TX, Rolesville NC Possible Relatives: Carole D High, Benjamin Paul Stewart, Billy R Stewart
Adam F Stewart, age 41, Dallas, TX View Details
Cities: Dallas TX Possible Relatives: Adam Stewart, Billie Frank Stewart, Jacqueline Mae Stewart
Adam George Stewart, age 44, Dallas, TX View Details
Cities: Dallas TX, Plano TX Possible Relatives: Aleks Stewart, Aleksandra Anna Stewart, Jeralyn Sue Stewart
Adam Gregory Stewart, age 40, Helotes, TX View Details
Cities: Helotes TX, San Antonio TX, Plymouth IN Possible Relatives: Amy Catherine Johnson, Amanda Kay Stewart, Gregory J Stewart
Adam Stewart, age 30s View Details
Possible Relatives: Jacob A Stewart, Laura S Stewart, Robert J Stewart
Adam N Stewart, age 30s View Details
Possible Relatives: Alex K Stewart, Bonnie J Stewart, Chandra N Stewart
Adam Clayton Stewart, age 30s View Details
Possible Relatives: Denise C Baker, Charles Turner Stewart, Charles Keith Stewart
Adam Stewart, age 40s, Monroe, IN View Details
Locations: Monroe IN, Decatur IN Possible Relatives: Dawn M Saunders, Elizabeth M Stuart, Janice M Stuart
Adam Wayne Stewart, age 40s, Roswell, NM View Details
Locations: Roswell NM, Midland TX, Houston TX
Adam J Stewart, age 40s, Kalamazoo, MI View Details
Locations: Kalamazoo MI, Pleasant Ridge MI Possible Relatives: Stacey Ann Callahan, Cassandra R Stuart, Craig Thomas Stuart
Adam Stewart, age 70s, Lubbock, TX View Details
Locations: Lubbock TX Possible Relatives: John Harrison Chinn, Holly Caitlin Maxey, Adam Lee Stewart
Adam I Stewart, age 100s, Oakwood, OH View Details
Locations: Oakwood OH, Dayton OH Possible Relatives: Blanche S Adam, Adam I Stewart
Adam Bradley Stewart, Arvada, CO View Details
Locations: Arvada CO, Broomfield CO Possible Relatives: Shannon M Herndon, Erica L Spry, Amie C Stewart
Adam R Stewart, age 38 View Details
Address:***** Spicewood Springs Rd, Apt 1x, Austin, TX. Phone Number: (512) 587-****
Adam M Stewart, age 31 View Details
Address:***** Gingerlily Cv, Unit A, Austin, TX. Phone Number: (210) 860-****
Adam M Stewart, age 42 View Details
Address:***** Haileys Run, Montgomery, TX. Phone Number: (713) 204-****
Adam W Stewart, age 29 View Details
Address:***** Valburn Dr, Austin, TX. Phone Number: (512) 694-****
Adam Stewart, age 28 View Details
Address:***** Zephyr Cir, Ingleside, TX. Phone Number: (361) 205-****
Adam L Stewart, age 46 View Details
Address:***** Vanderbilt Ave, Dallas, TX. Phone Number: (214) 824-****
Adam S Stewart, age 41 View Details
Address:***** Avenue B, Austin, TX. Phone Number: (512) 669-****
Address:***** Memorial Dr, Apt 7xx, Houston, TX. Phone Number: (832) 538-****
Search locality history, phone, age and more.

Adam Stewart • AdamG_Stewart

Adam Stewart • adamstewart466

Adam Stewart • AdamGoogleUK

Adam Stewart • AdamIanStewart

Adam Stewart • AdamStewart

Adam Stewart • InvolveAdam

Adam Stewart • a_stewart7

Adam Stewart • adamstewart_19
Adam Stewart • adm_stewart

Adam Stewart • stew_adam

Adam Ant • adamaofficial

Adam S. Smith • AdamStuartSmith

Adam • itsAdamStewart

Adam Stewart ATC DPT • thestewpot2

Adam Stewart 🏳️🌈 • RAdamStewart

Adam Stewart 💚 🌹 • adam_stewart

Adam Stewart, Realtor® | Www.adamstewart.realtor • Adam_Stewart_

Adam Stewart • Adderallniter

Adam Stewart • adamst45504

Adam Stewart • adamstewart70



![[ßåssFåçë] - Myspace Profile Picture of [ßåssFåçë] (@blackened_wing) on Myspace](https://pkimgcdn.peekyou.com/37ec8425aa9069d752d3be6e6818bbce.jpeg)


jesus¦christ¦almighty¦bean¦child, age 24 • adam_stewart
Folkestone, South, United Kingdom
24 years old.

Adam Stewart (business executive)
Adam Stewart is a Jamaican businessman. He is the Chairman of the Caribbean-based resort company Sandals Resorts International (SRI), the ATL Group, a Jamaica-based automotive and commercial and domesread more...

Adam Stewart is a New Zealand male track cyclist, riding for the national team. He competed in the team sprint event at the 2010 UCI Track Cycling World Championships.

Adam Stewart may refer to:Adam Steuart or Stewart, Scottish philosopher and controversialist Adam Stewart, Jamaican businessman Adam Stewart (cyclist), New Zealand track cyclist

Adam Steuart (1591–1654) was a Scottish philosopher and controversialist.

Stewart Alexander "Stew" Adams was a professional ice hockey player in the National Hockey League.
Adam Stewart | Galerie Zuger | Dallas Texas
www.galeriezugerdallas.com › artists › adam_stewart › CB1207101212.html
www.adamstewart.com › shows.htm
www.adamstewart.net › calendar.html
adamstewartart.com › shows.html
"BRYCE ADAM STEWART" | Search Lubbock, Texas | Lubbock Online ...
search.lubbockonline.com › fast-elements.php%3Ftype%3Dstandard%26profile%3Dlubbock%26querystring%3D%2522BRYCE%2520ADAM%2520STEWART%2522
Adam K. Stewart, M.D. - Scott & White - Central Texas
www.sw.org › web › researchAndEducation › templatedata › hr › resident › data › res_stu › res_stewart_ak
Adam Stewart | Obscurities Tattoo & Piercing
www.obscurities.com › tattoos › adam
Adam Stewart (Adam) on Myspace
www.myspace.com › svtstyle
Art By Adam Stewart | Facebook
www.facebook.com › AdamStewartArt
What's Adam Stewart's address in Texas?
Adam Stewart's address is ***** Spicewood Springs Rd, Apt 11, Austin, TX.
What's Adam Stewart's age?
Adam Stewart's age is 38.
What's Adam Stewart's phone number?
Adam Stewart's phone number is (512) 587-****.
What's Adam Stewart's from Texas famous for?
Adam Stewart is a Jamaican businessman. He is the Chairman of the Caribbean-based resort company Sandals Resorts International (SRI), the ATL Group, a Jamaica-based automotive and commercial and domestic appliance distributor and President of the Sandals Foundation, the philanthropic arm of Sandals Resorts International.. You can find more here.
Are PeekYou social results accurate?
PeekYou is a free people-focused search engine that uncovers information typically buried by other search engines. Its clean and user-friendly format makes it easy to navigate. The platform offers accurate data and conveniently links to an individual's social media profiles and other public websites with which they are associated.